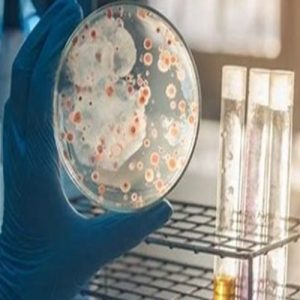
Bacteria-Culture

Bacteria Culture
Bacteria Culture
We have carved out a distinct and dynamic presence in the market by delivering a premium range of Bacteria Culture. Leveraging cutting-edge technology and the finest chemical compounds, our experts ensure these products are of the highest quality. Their exceptional attributes have made them highly sought after across multiple industries. Furthermore, we offer these products in a variety of packaging options, all at competitive prices, ensuring great value for our esteemed clients.
Contact Us
406, SWC HUB, Vasna Bhayli Road, Vadodara Gujarat- 391014
Get Connected
Give Us a Call
9428402824
Open Hours
10.00 am–19.00 pm









